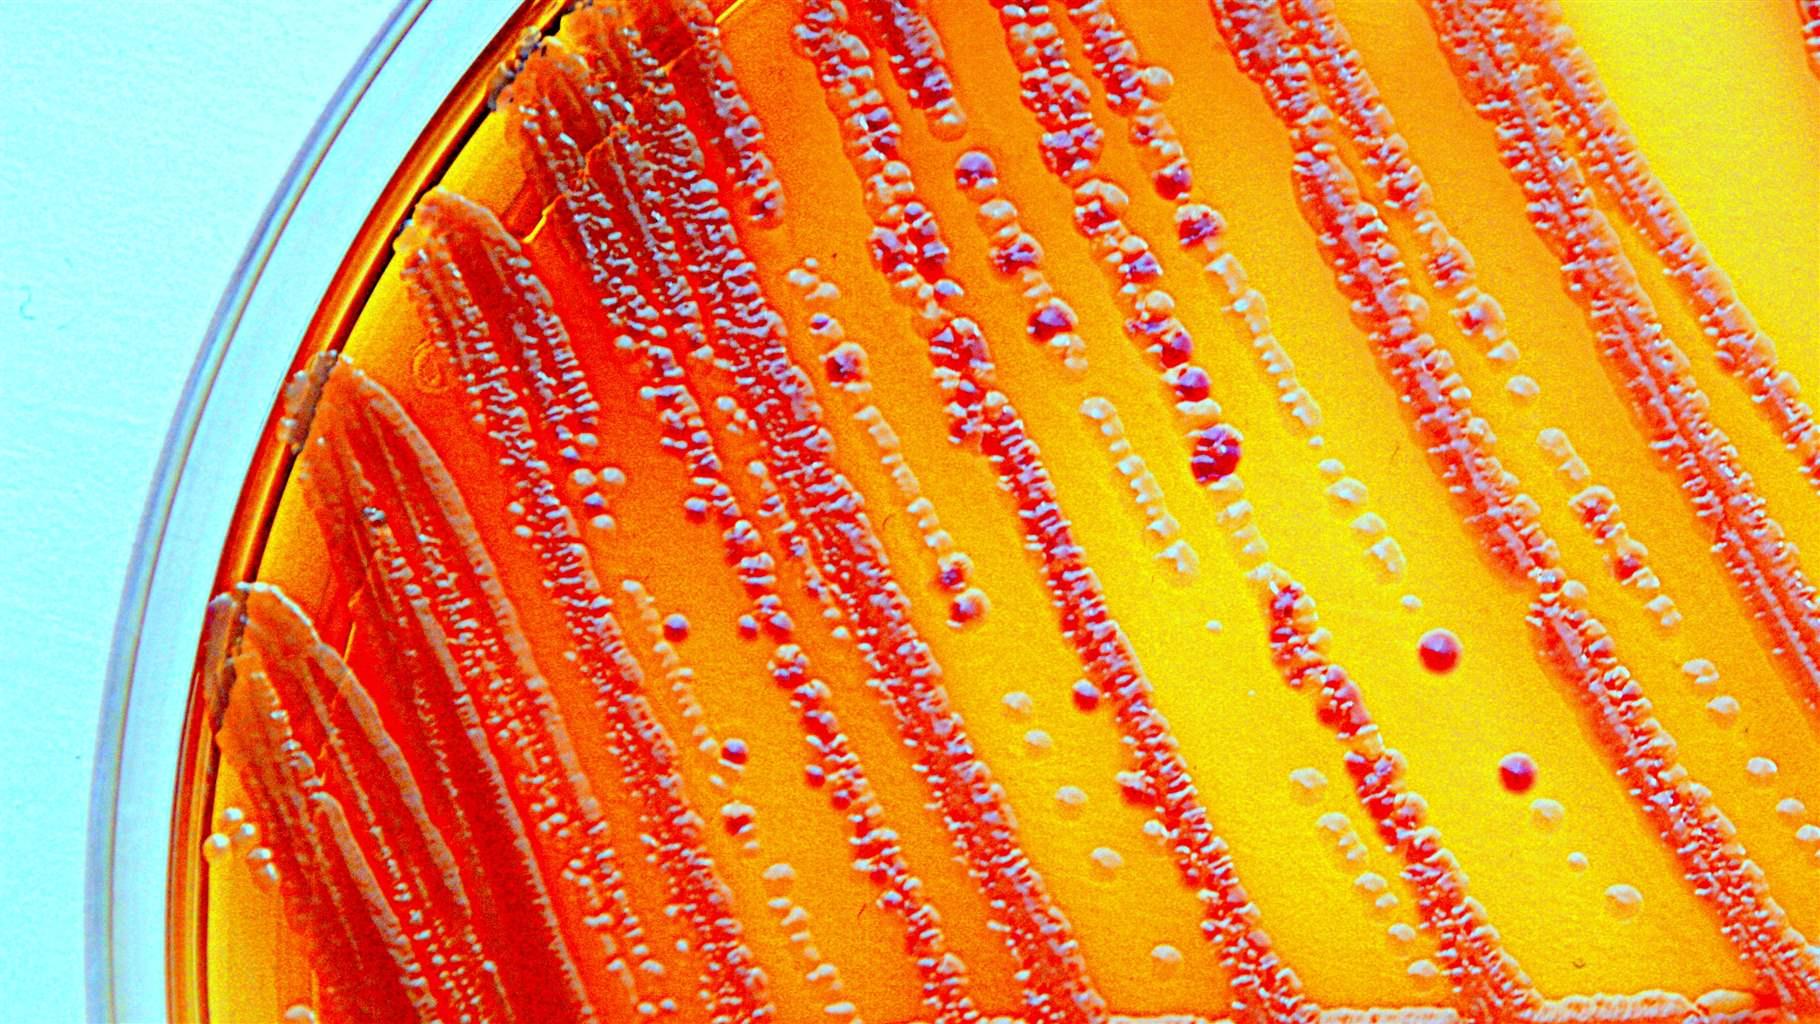

Enterobacter kobei
Enterobacter kobei 116 фото
Шапочка для бассейна на озон
Подписка телефона на рекламу
Инофта хондроитина сульфат
Как взрослому научиться играть на пианино
Респеро миртол форте 300 мг
I rather like you
Слушай песенки серенькая кошечка
Край отложить
Компания итк
Сестра фиби